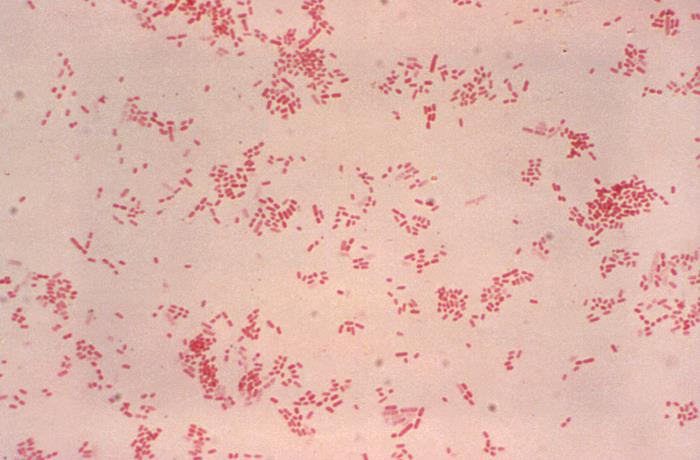

你了解巴斯德菌嗎?生物顯微鏡如何檢測|應(yīng)用百科
你了解巴斯德菌嗎?生物顯微鏡如何檢測|應(yīng)用百科
巴斯德菌是一種革蘭氏染色陰性菌,常寄生于狗、貓、家禽、鳥類等動(dòng)物的呼吸道和消化道黏膜??梢鸺仪莼魜y、出血性敗血癥,以及人的腦膜炎、敗血癥等疾病。那么如何檢測巴斯德菌?可采用細(xì)菌培養(yǎng)和生物顯微鏡鏡檢。
一、細(xì)胞培養(yǎng)

在哥倫比亞瓊脂平板上形成直徑為1~2 mm、不透明、淺灰色菌落
二、生物顯微鏡鏡檢
經(jīng)革蘭染色,在生物顯微鏡ML51-N下,呈小桿菌或球桿菌,單個(gè)存在,有時(shí)成對或短鏈;無芽孢、無鞭毛。

巴斯德菌在生物顯微鏡ML51-N下的觀察主要涉及形態(tài)結(jié)構(gòu)和染色特性的觀察;ML51-N是一款研究級生物顯微鏡,采用優(yōu)質(zhì)的無限遠(yuǎn)獨(dú)立消色差光學(xué)設(shè)計(jì),支持光強(qiáng)管理器,可在低倍到高倍成像獲得一致的照明亮度,超大視野目鏡,鏡檢效率更高,尤其適合巴斯德菌等需要高倍油鏡觀察的樣品。
如果您對巴斯德菌顯微鏡感興趣或有疑問,歡迎與我們聯(lián)系,期待與您相約!
本文網(wǎng)址:http://m.lwrxzj.com/kehuanli/20240805.html,轉(zhuǎn)載請保留出處,謝謝!
相關(guān)文章閱讀推薦: